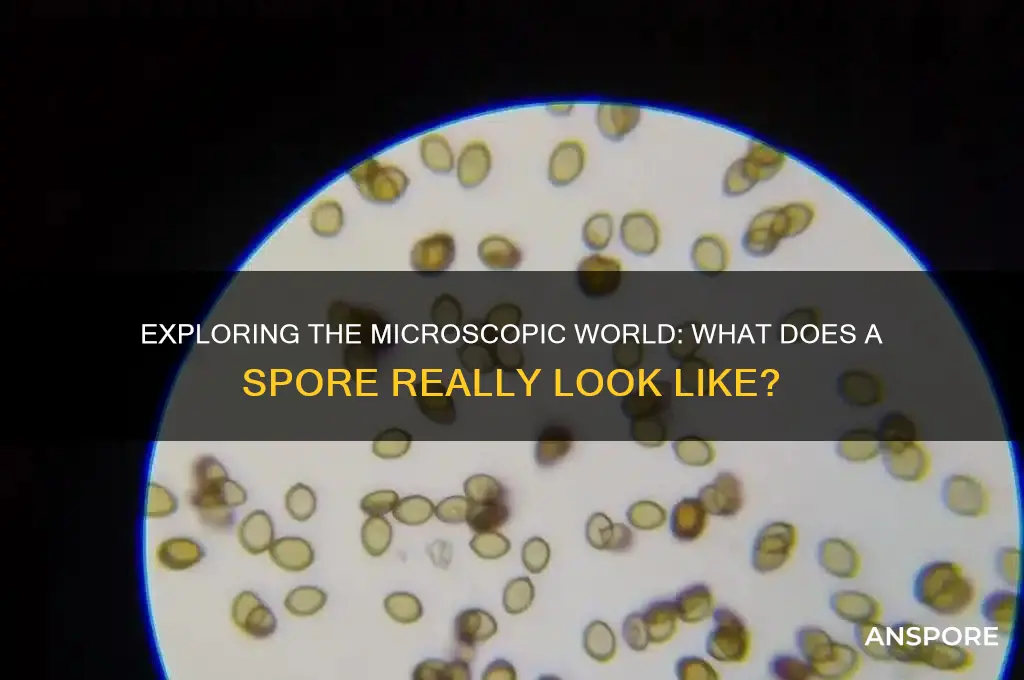
what does a spore look like

Spores are microscopic, single-celled reproductive structures produced by plants, fungi, and some bacteria, designed to survive harsh conditions and disperse widely. Typically ranging from 2 to 50 micrometers in size, they are often too small to see with the naked eye but can be observed under a microscope. Spores vary in shape, color, and texture depending on the organism; for example, fungal spores may appear as smooth, round cells or elongated structures with intricate patterns, while plant spores, like those from ferns or mosses, can be more angular or winged for wind dispersal. Their appearance is often adapted to their specific environment and method of propagation, making them fascinating yet diverse in form.
| Characteristics | Values |
|---|---|
| Size | Typically 1-50 micrometers (μm) in diameter, depending on the species. |
| Shape | Varies widely; common shapes include spherical, oval, cylindrical, or elongated. |
| Color | Often colorless or translucent when immature; may turn brown, black, green, or other colors when mature. |
| Wall Structure | Composed of a tough, protective outer layer called the spore wall (exospore), which can be smooth, ornamented, or layered. |
| Surface Texture | Can be smooth, rough, spiny, or warty, depending on the species. |
| Appendages | Some spores have appendages like elaters (spring-like structures) or hairs that aid in dispersal. |
| Contents | Contains a nucleus, cytoplasm, and stored nutrients; may also have pigments or lipids. |
| Resistance | Highly resistant to environmental stresses such as heat, desiccation, and radiation due to the thick spore wall. |
| Germination | Remains dormant until favorable conditions trigger germination, leading to the growth of a new organism. |
| Dispersal | Dispersed by wind, water, animals, or other means, depending on the species. |
| Examples | Fungal spores (e.g., mushrooms), bacterial spores (e.g., Bacillus anthracis), and plant spores (e.g., ferns, mosses). |
Explore related products
What You'll Learn
- Spore shape and size variations across different species and environments
- Surface textures: smooth, rough, or ornamented, depending on the organism
- Color range: from translucent to dark, often species-specific hues
- Spore wall structure: single or multi-layered, protective outer coatings
- Appendages: presence of tails, wings, or other spore dispersal features

Spore shape and size variations across different species and environments
Spores, the microscopic survival units of various organisms, exhibit remarkable diversity in shape and size, reflecting their evolutionary adaptations to specific environments and dispersal mechanisms. For instance, fungal spores often range from 1 to 100 micrometers in diameter, with shapes varying from spherical (e.g., *Aspergillus*) to elongated or cylindrical (e.g., *Fusarium*). These variations are not arbitrary; spherical spores maximize volume for nutrient storage, while elongated forms may aid in wind dispersal or attachment to surfaces. In contrast, fern spores are typically smaller, around 50 micrometers, and exhibit intricate patterns like tetrahedral or kidney shapes, which enhance their aerodynamic properties for long-distance travel.
Consider the environment’s role in shaping spore characteristics. In arid regions, spores tend to be smaller and more resilient, often with thick walls to withstand desiccation. For example, *Clostridium* bacterial spores, found in soil, are oval and measure 0.5 to 1.5 micrometers, with a durable outer layer that enables survival in harsh conditions. Conversely, aquatic spores, such as those from algae, are frequently larger and less dense, allowing them to remain suspended in water for extended periods. This environmental tailoring highlights how spore morphology is a direct response to survival pressures.
To observe these variations, use a compound microscope with at least 400x magnification. Prepare a wet mount by placing a drop of water or stain (e.g., lactophenol cotton blue for fungi) on a slide, adding a spore sample, and covering with a coverslip. Note how *Penicillium* spores appear as chains of green, cylindrical structures, while *Bacillus* bacterial spores are oval and refract light distinctly. For ferns, collect spores from the underside of mature fronds and observe their geometric patterns under magnification. This hands-on approach reveals the subtle yet profound differences in spore design.
From an evolutionary standpoint, spore shape and size are critical for dispersal and germination success. Wind-dispersed spores, like those of dandelions, are lightweight and often winged or hairy, enabling them to travel kilometers. In contrast, water-dispersed spores, such as those from mosses, are smooth and buoyant. Animal-dispersed spores, like those of certain fungi, may have sticky surfaces or hooks to attach to fur or feathers. These adaptations underscore the interplay between form and function in spore biology, making them a fascinating subject for both scientific study and practical observation.
Do Angiosperms Produce Spores? Unveiling the Truth About Seed Plants
You may want to see also

Surface textures: smooth, rough, or ornamented, depending on the organism
Spores, the resilient reproductive units of various organisms, exhibit a striking diversity in surface textures that serve both functional and ecological purposes. From the smooth, almost glass-like surfaces of certain fungal spores to the intricately ornamented exteriors of fern spores, these textures are not merely aesthetic but often dictate survival strategies. For instance, smooth spores, like those of *Aspergillus*, minimize friction, aiding in wind dispersal. In contrast, the rough, warty surfaces of *Rust* fungi enhance adhesion to host plants, ensuring successful infection. This variation underscores the evolutionary precision with which spores are designed to thrive in their environments.
When examining spore textures under a microscope, one can observe how these features influence interactions with the environment. Ornamented spores, such as those of *Polypodium* ferns, often feature ridges, spines, or reticulations that increase surface area, facilitating water retention in arid conditions. This adaptation is critical for germination in unpredictable climates. Conversely, the ultra-smooth spores of *Penicillium* fungi reduce water adhesion, preventing clumping and promoting airborne dispersal. For enthusiasts or researchers, noting these textures can provide clues about a spore’s dispersal mechanism and habitat preferences.
Practical applications of understanding spore textures extend beyond curiosity. In agriculture, identifying rough-surfaced spores of plant pathogens like *Puccinia* (wheat rust) can inform targeted fungicide application, as these spores are more likely to adhere to leaf surfaces. Similarly, in forensic mycology, spore textures can help trace contamination sources—smooth spores may indicate indoor mold, while ornamented spores suggest outdoor exposure. For hobbyists cultivating mushrooms, recognizing the smooth, spherical spores of *Agaricus* species can aid in accurate identification and cultivation.
To study spore textures effectively, start with a compound microscope at 400x magnification, using a clear slide and a drop of water or glycerin to mount the sample. For rough or ornamented spores, consider adding a small amount of cotton blue stain to highlight surface features. Smooth spores may require phase-contrast microscopy to discern subtle details. Always handle spore samples with care, especially those of pathogenic organisms, and ensure proper ventilation to avoid inhalation. By mastering these techniques, one can unlock a deeper appreciation for the microscopic world’s architectural marvels.
In conclusion, spore surface textures—smooth, rough, or ornamented—are not arbitrary but finely tuned adaptations that reflect an organism’s ecological niche. Whether aiding dispersal, enhancing adhesion, or conserving moisture, these textures offer insights into spore biology and practical applications across fields. By observing and understanding these microscopic details, we gain a greater respect for the ingenuity of nature’s designs.
Can Heat Kill Mold Spores? Effective Temperatures and Methods Explained
You may want to see also

Color range: from translucent to dark, often species-specific hues
Spores exhibit a remarkable spectrum of colors, ranging from nearly invisible translucence to deep, dark shades, each hue often tied to the specific species producing it. This diversity is not merely aesthetic; it serves functional purposes such as protection from UV radiation, camouflage, or even attracting dispersal agents. For instance, the translucent spores of certain ferns blend seamlessly into their environment, while the dark, almost black spores of some fungi absorb heat more efficiently, aiding in germination. Understanding this color range is crucial for identification, as it often provides the first visual clue to a spore’s origin.
To observe this color range effectively, use a magnifying glass or microscope, as spore sizes typically range from 5 to 50 micrometers. Translucent spores, like those of *Sphagnum* moss, may appear as faint specks under low magnification, requiring higher resolution to discern their structure. In contrast, darker spores, such as those of *Coprinus* mushrooms, are immediately visible due to their pigment density. For accurate identification, compare your observations to species-specific color charts or databases, which often categorize spores as hyaline (translucent), pale yellow, brown, or black. Note that environmental factors like humidity or age can alter spore color, so fresh samples yield the most reliable results.
The species-specific nature of spore color makes it a valuable diagnostic tool in botany and mycology. For example, the rust-colored spores of *Puccinia* fungi are distinct from the pale green spores of *Marchantia* liverworts. This specificity extends to practical applications, such as forensic analysis, where spore color can link evidence to a particular plant or fungus. When collecting samples, avoid contamination by using sterile tools and storing spores in airtight containers. For educational purposes, create a spore color palette by mounting samples on slides and labeling them with their corresponding species, providing a visual reference for future study.
While spore color is a key identifier, it should not be the sole criterion. Combine color observations with other characteristics like shape, size, and surface texture for precise classification. For instance, two species may have similarly dark spores but differ in their ornamentation or germination patterns. Additionally, consider the ecological context: spores found in shaded environments may prioritize translucence for light absorption, while those in open areas might develop darker pigments for UV protection. By integrating color analysis with broader morphological and ecological data, you can unlock a deeper understanding of spore diversity and function.
Exploring Nature's Strategies: How Spores Travel and Disperse Effectively
You may want to see also
Explore related products

Spore wall structure: single or multi-layered, protective outer coatings
Spores, the resilient survival units of certain plants, fungi, and bacteria, owe their durability to their protective outer coatings. This spore wall, a critical structure, can be single or multi-layered, each design tailored to the organism's survival needs. A single-layered wall, often found in some fungal spores, provides a basic barrier against environmental stresses like desiccation and UV radiation. In contrast, multi-layered walls, common in bacterial endospores, offer enhanced protection through specialized layers such as the exosporium, coat, and cortex, each contributing unique defensive properties.
Analyzing the composition of these layers reveals their functional brilliance. For instance, the exosporium in bacterial endospores acts as a sieve, regulating the entry of molecules, while the cortex contains peptidoglycan, which absorbs heat and protects the spore’s core. Multi-layered walls are not just about thickness; they are about strategic defense mechanisms. For example, the coat layer in endospores is rich in proteins that resist enzymes and chemicals, making the spore nearly indestructible under harsh conditions. This complexity highlights the evolutionary sophistication of spore design.
If you’re studying spores or working in fields like microbiology or botany, understanding wall structure is crucial. Single-layered spores, though less complex, are easier to study under a microscope, often revealing distinct textures or patterns. Multi-layered spores, however, require advanced techniques like electron microscopy to discern their intricate architecture. Practical tip: When preparing slides, use staining techniques like safranin or malachite green to highlight different layers, especially in bacterial endospores, for clearer visualization.
Comparatively, the choice between single and multi-layered walls reflects the organism’s ecological niche. Fungal spores with single-layered walls are often airborne, prioritizing lightweight design for dispersal. Bacterial endospores, however, are built for endurance, capable of surviving extreme temperatures, radiation, and chemicals. This comparison underscores the principle that form follows function in spore biology. For enthusiasts or educators, illustrating this with diagrams or models can make the concept more tangible.
In conclusion, the spore wall’s structure—whether single or multi-layered—is a masterclass in biological engineering. It’s not just a barrier but a multi-functional shield, tailored to the organism’s survival challenges. By examining these structures, we gain insights into the resilience of life and practical knowledge for fields ranging from medicine to agriculture. Whether you’re a researcher or a curious learner, the spore wall invites you to explore the microscopic marvels of nature’s design.
Identifying Black Mold Spores on Leather: Appearance and Detection Tips
You may want to see also

Appendages: presence of tails, wings, or other spore dispersal features
Spores, the microscopic survival units of various organisms, often exhibit specialized appendages that enhance their dispersal capabilities. These structures, such as tails, wings, or other adaptations, are nature’s ingenious solutions to the challenge of spreading across vast distances. For instance, certain fungal spores develop long, filamentous tails that increase their surface area, allowing them to be carried farther by air currents. Similarly, some plant spores, like those of ferns, feature elastic hairs that coil and uncoil in response to humidity changes, propelling the spores into the air. These appendages are not merely decorative; they are functional tools that maximize the spore’s chances of reaching a suitable environment for germination.
To understand the role of these appendages, consider the lifecycle of a spore. Dispersal is critical for survival, as spores must escape their parent organism and travel to new habitats. Wings, though rare, are found in some fungal spores, such as those of the genus *Aspergillus*. These wing-like extensions create lift, enabling the spores to remain airborne longer. Tails, on the other hand, often serve a dual purpose: they increase drag, keeping the spore aloft, while also acting as anchors when the spore lands. For example, the spores of the water mold *Phytophthora* have whip-like tails that help them swim through water, ensuring they reach susceptible plant roots. Each appendage is tailored to the spore’s environment, demonstrating a remarkable level of evolutionary precision.
When examining spores under a microscope, look for these appendages as key identifiers. Tails, often called flagella, are more common in water-dispersed spores and appear as thin, hair-like projections. Wings or flanges, though less frequent, are visible as flat, blade-like extensions. Practical tip: Use a 40x to 100x magnification to observe these structures clearly, and note their arrangement—some spores have a single tail, while others have multiple. For educational purposes, compare spores from different species to highlight how appendages vary based on dispersal needs. For instance, contrast the winged spores of *Aspergillus* with the tailless, smooth spores of *Penicillium* to illustrate adaptation diversity.
The presence of appendages also has implications for controlling spore-borne diseases. In agriculture, understanding how spores disperse can inform strategies to limit their spread. For example, spores with tails are more likely to thrive in wet conditions, so reducing moisture can inhibit their movement. Conversely, winged spores are more prevalent in dry, windy environments, making windbreaks an effective preventive measure. Dosage of fungicides or other treatments should be adjusted based on the spore type and its dispersal mechanism. For instance, water-based sprays are more effective against tailless spores, while airborne treatments may be necessary for winged varieties.
In conclusion, appendages like tails, wings, and other dispersal features are not just fascinating aspects of spore biology but also practical indicators of how spores interact with their environment. By studying these structures, we gain insights into spore behavior, which can be applied in fields ranging from botany to medicine. Whether you’re a researcher, educator, or hobbyist, recognizing and understanding these appendages will deepen your appreciation of the microscopic world and its intricate survival strategies.
Spore Syringe Shelf Life: Room Temperature Storage Duration Explained
You may want to see also
Frequently asked questions
Under a microscope, spores often appear as small, round, or oval structures, ranging in size from 1 to 50 micrometers. They may have a smooth or textured surface, depending on the species, and can vary in color from translucent to dark.
Most individual spores are too small to be seen without magnification, but in large quantities, they may appear as a fine, powdery or dusty substance, often white, green, or black, depending on the type of organism producing them.
No, spores vary widely in appearance depending on the organism. For example, fungal spores may have distinct shapes or appendages, while bacterial spores (like those of *Bacillus*) are typically oval and highly resistant. Plant spores, such as those from ferns or mosses, also have unique structures adapted for dispersal and survival.






























